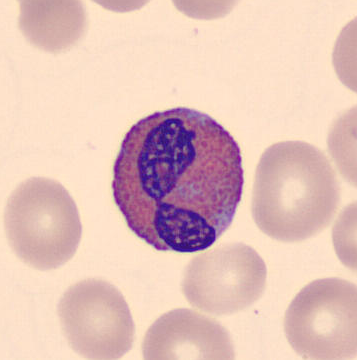

Project Gallery
You didn’t come this far to stop. Scroll Down to see All my professional endevours and be sure to text me about any of them!
Technical/Research Projects
Explore the projects showcasing my software development skills and experience.
WBC Classification using SSL
Implemented a self-supervised learning pipeline for WBC classification of 5 main types by training an autoencoder on large scale datasets to learn morphological features and cell characteristics.

Sports Field Detection
Developed and implemented an object detection pipeline on satellite imagery to identify and classify 5 types of sports fields using YOLO and RT-DETR models
Autoencoder Visual via Sky engine AI




Automated Link Monitoring System
Developed a full-stack link monitoring platform with a serverless backend on Google Cloud.


Multi Source Business Analytics System
Designed and implemented a scalable ETL pipeline ingesting real-time event data from various sources via Make.com


Academic Projects
Explore the projects showcasing my software development skills and experience.
Mini Search Engine
latest tech solving codes such as mini search engine and airplane traffic control system






Audio Classification Tool
State of the art machine learning models help solving real world quarries and problems
